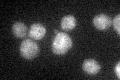
YNL130C
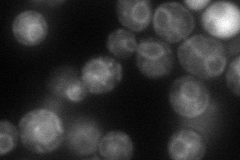
YNL130C
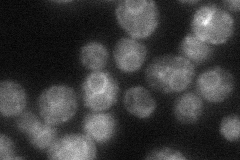
YNL130C
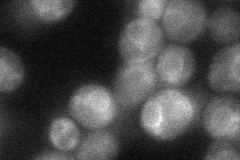
YNL130C
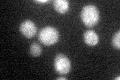
YNL130C

View description
Cholinephosphotransferase, required for phosphatidylcholine biosynthesis and for inositol-dependent regulation of EPT1 transcription
Localization:
Intensity:
Fold change:
Significance:
-
C’ GFP library in SD
Nuclear periphery30.42 -
N' NOP1pr-GFP in SD
ER68.0548 -
N' TEF2pr-mCherry in SD

ER,vacuole163.358 -
N' NATIVEpr-GFP in SD
ER49.7444 -
N' TEF2pr-VC and Cyto-VN in SD
ER40.2705 -
C’ GFP library in SD+DTT
Nuclear periphery20.260.66Yes -
C’ GFP library in SD+H2O2

Nuclear periphery24.020.78No -
C’ GFP library in Starvation Media

Nuclear periphery30.220.99No -
C’ GFP library on the background of Pup2-DaMP

Nuclear periphery -
C’ GFP library on the background of CCT mutant

Nuclear periphery23.95960.787415No
